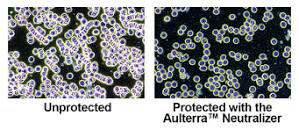

Protect your families against harmful EMF, (The electric-magnetic field). I only found out about it lately with the COVID 19 virus and how the overuse of a New technology 5G may be causing damage to our DNA, making us more vulnerable to viruses and damage our overall health with invisible microwaves. We have grown used to the cell phones, but now this technology is way stronger. But you must educate yourself about the EM fields from all your devices and then find a way to help make you and your family safer.
Aulterra products are scientifically proven, patented, published, and peer-reviewed offering the best protection against the harmful effects of 5G and EMF. These are the tests of protected and unprotected images of a person using a cell phone. Unprotected cells are clumped together. When I saw this it was a no brainer for me I had to try it. What do I have to lose, and it is really affordable to purchase the products.
Order Now

Comments
Post a Comment